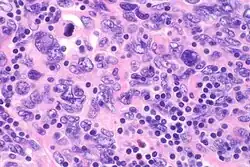

Follicular dendritic cell sarcoma
| Follicular dendritic cell sarcoma | |
|---|---|
![]() | |
| Micrograph showing a follicular dendritic cell sarcoma. The cancer cells are larger and have pale staining nuclei. The smaller (benign) interspersed lymphocytes (darker blue) are common and suggest the diagnosis. H&E stain. | |
| Specialty | Oncology |
Follicular dendritic cell sarcoma (FDCS) is an extremely rare neoplasm. While the existence of FDC tumors was predicted by Lennert in 1978, the tumor wasn't fully recognized as its own cancer until 1986 after characterization by Monda et al.[1][2] It accounts for only 0.4% of soft tissue sarcomas, but has significant recurrent and metastatic potential
| Follicular dendritic cell sarcoma tumor | |
|---|---|
| Specialty | Oncology |
and is considered an intermediate grade malignancy.[3] The major hurdle in treating FDCS has been misdiagnosis. It is a newly characterized cancer, and because of its similarities in presentation and markers to lymphoma, both Hodgkin and Non-Hodgkin subtypes, diagnosis of FDCS can be difficult.[4] With recent advancements in cancer biology better diagnostic assays and chemotherapeutic agents have been made to more accurately diagnose and treat FDCS.
Signs and symptoms
Follicular dendritic cells are localized in germinal centers of lymphoid follicles and have an integral role in regulation of the germinal center reaction and present antigens to B cells.[5][6] Most cases of FDCS develop in the lymph nodes, but about 30% develop in extranodal sites. In 1998 the largest study on the disease was a retrospective review with fifty-one patients.[7] Of these fifty-one patients, no conclusive pattern was found in regard to age, sex, race or presentation. The median patient age was 41 (range 14–76), and while most cases presented with cervical and axillary lymphadenopathy, 17 presented in extranodal sites including the liver, spleen, bowel and pancreas.[7] With such a range of patient histories no definitive cause has been linked to FDCS. There has, however, been some evidence that previous exposure to the Epstein–Barr virus (EBV) or diagnosis of Castleman's disease can increase the risk of developing FDCS—medical literature in 2000 reported approximately 12% of all cases of FDC tumors are associated with EBV, with variance in different organs, but the role of EBV remains unclear in FDC tumor pathogenesis; and EBV does not appear to play a role in the transformation process of Castleman's disease to FDC sarcoma because all cases the report found associated with Castleman's disease were EBV negative.[8][9][10]
Symptoms of FDCS vary, and are largely dependent on the part of the body in which the tumor develops. The most common symptom is painless swelling in lymph nodes. This symptom alone, however, is nonconclusive, as it is associated with many other diseases, including the common cold. Other symptoms include cough, sore throat, difficulty swallowing, weight loss and tiredness. In cases that present in extranodal sites outside of the head and neck region, organ specific symptoms are observed.
Diagnosis
Staining
Proliferation of FDC cells is characteristic of many neoplastic conditions including follicular hyperplasia, follicular lymphoma, nodular lymphocyte predominate Hodgkin's disease and angioimmunoblastic T-cell lymphoma.[11] Despite finally being recognized as its own disease in 1986, diagnosis of FDCS is still difficult. FDC cells are large, contain two nuclei, and form clusters with lymphocytes making them difficult to distinguish in staining. These cells are best visualized with immunostaining using the FDC markers CD21, CD35, R4/23, clusterin, and KiM4p.[11] Marker analysis has also led to debate over the origin of the cell type; it coexpresses CD45, a leukocyte common antigen, and CD15, a monocyte common antigen.[7] Because of the debate and difficulty of staining, pathologic diagnosis often requires morphologic, cytochemical and electron microscope analysis as well.[7]
Cellular mutations
Cellular abnormalities found within the FDCS tumor have been exploited for diagnostic purposes. Characteristically, FDCS have mircotubuloreticular structures (MTRS) and increased levels of intracellular clusterin.[12][13] MTRS contribute to microtubule formation of many structures, including the mitotic spindle, during cell division. This contributes to many of the hallmarks of cancer, including proliferative signaling, growth activation, and replicative immortality.[14] Clusterin is a heterodimeric protein that aids in the clearance of cellular debris and is involved with apoptosis. Clusterin can be stained to help distinguish FDCS and is involved in the many important cancer hallmarks, including resistance to cell death and evading growth suppressors.[14]
Treatment
CHOP
At the time of the follicular dendritic cell sarcoma discovery, information on the effect of chemotherapy and radiation on it was nonexistent. The best physicians could do was try existing chemotherapeutic agents. With no evidence of the clinical benefit of chemotherapy, many of the first cases were treated solely with complete resection and/or radiation. However, 12 of 31 patients who had surgery alone as primary treatment relapsed.[7] Of the patients who received surgery and radiation, 2 of 8 relapsed.[7] It became apparent that better treatment options were necessary. Being so similar to lymphomas, physicians began using a common leukemia and non-Hodgkin's lymphoma chemotherapy regimen on FDCS patients: CHOP.

The CHOP regimen consists of Cyclophosphamide, Doxorubicin, Oncovin, and Prednisone (CHOP). They all exploit different pathways common in cancer cells. Cyclophosphamide slows or stops cell growth. It targets cells that are rapidly dividing, which include cancer cells that are self-sufficient in growth signals and insensitive to antigrowth signals. More importantly, the biological actions of cyclophosphamide are dose-dependent.[15] At high doses it is very cytotoxic; its metabolite phosphoromide adds an alkyl group to the N7 position on guanine resulting in arrested growth and cell death. The metabolite is only formed in cells with low levels of cytoplasmic aldehyde dehydrogenase (ALDH), resulting in relatively low chemotherapeutic toxicity in other non-cancer cells like bone marrow. It is also an immunosuppressant and decreases the inflammatory response. At low doses, while it is less cytotoxic, it shows some anti-angiogenic properties. The mechanism is not fully understood; it is thought that it interferes with the VEGF growth factors produced in and around the tumor microenvironment.[16]
Doxorubicin interferes with cell growth and replication by intercalating in DNA. This stops topoisomerase II from relaxing the DNA strands and inhibits transcription. Recent studies have also shown that doxorubicin may be involved in the PI3K/AKT/mTOR pathway.[17] An important hallmark of cancer, Akt is part of the cell survival pathways by inhibiting apoptosis. There is also evidence that Akt is involved in angiogenesis and vascular maturation.[18] Activation of the PI3K/AKT/mTOR pathway mediates VEGF production in cells.[18] Therefore, doxorubicin has a dual role in cancer treatment: it inhibits cell survival (causes apoptosis), and decreases angiogenesis.
Oncovin, more commonly known as vincristine, is a mitotic inhibitor. It binds to tubulin dimers, inhibiting the assembly of microtubule structures like the cytoskeleton and mitotic spindle. Although this drug still cannot strictly target cancer cells, cancer cells have a higher average turnover of microtubules making them more susceptible to the cytotoxicity of oncovin. Prednisone, the last drug in the CHOP combination therapy is a corticosteroid that acts as an immunosuppressant.
Although some results were seen in FDCS patients treated with CHOP, they were far from consistent. Using a chemotherapy regimen designed for another cancer is an archaic "guess-and-check" way of treating a disease. In 2008 the largest review of FDCS was published as a retrospective analysis on 98 patients and the authors recommended that surgery with no adjuvant treatment be the standard for FDCS treatment.[19] Patients treated with surgery alone had a recurrence rate of 40% and those treated with adjuvant therapy after surgery did not have a significantly different recurrence rate.[19] Radiation and/or chemotherapy had no significant effect in improving patients' disease-free survival. With developments in our understanding of the hallmarks of cancer, however, novel approaches to specifically targeting and treating FDCS are being developed.
(PEG)-liposomal doxorubicin
One such development is in the delivery of doxorubicin. While it is an effective inducer of apoptosis, doxorubicin is quickly filtered out of the body. By loading a PEG-liposome with doxorubicin the circulation time and localization to tumors greatly increases.[3] Cancerous tumors characteristically have extensive angiogenesis and leaky vasculatures, which causes the PEG-liposomes to naturally accumulate in the tumor. This also allows for patients to receive lower and fewer doses of the drug and experience fewer side effects.
Taxotere and gemcitabine


Newer cases are also starting to be treated by taxotere and gemcitabine. Taxotere is similar to Oncovin used in CHOP; it irreversibly binds beta tubulin halting formation of microtubules. Taxotere has an added benefit though; it also phosphorylates bcl-2 to halt the anti-apoptotic pathway.[20] The dual effect of taxotere on integral cancer pathways makes it a more potent drug than Oncovin. Gemcitabene is a nucleoside analog and when incorporated into DNA during replication leads to apoptosis; the fluorine on the 2’ carbon atom stops other nucleosides from attaching.[21] The most important part of this combination therapy, however, is the synergism between the drugs. While researchers are not entirely sure of the mechanism, there is evidence of synergistic effects of taxotere and gemcitabine when used in combination.[22][23] This allows for decreased dosages of each single agent with an increased apoptotic response.
Research
All advances in the understanding and treatment of FDCS come from advances made in other cancers. Funding for research is hard to come by and being such a rare cancer FDCS does not receive monetary priority. CHOP, Gemcitabine, and Taxotere were all initially developed for other cancers, but mutually mutated pathways allow for its use in FDCS. The hallmarks of cancer have helped physicians realize that there are biological commonalities between seemingly very different cancer types that can be exploited to develop new and better treatment plans.[14]
References
- ^ Lennert, Karl (1978). Malignant lymphomas other than Hodgkin's disease, histology, cytology, ultrastructure, immunology. Berlin: Springer-Verlag. pp. 59–64. ISBN 978-0-387-08020-8.
- ^ Monda, Lauren; Warnke, Roger; Rosai, Juan (1986). "A primary lymph node malignancy with features suggestive of dendritic reticulum cell differentiation. A report of 4 cases". The American Journal of Pathology. 122 (3): 562–72. PMC 1888214. PMID 2420185.
- ^ a b Sharpe, Miriam; Easthope, Stephanie E.; Keating, Gillian M.; Lamb, Harriet M. (2002). "Polyethylene glycol-liposomal doxorubicin: a review of its use in the management of solid and haematological malignancies and AIDS-related Kaposi's sarcoma". Drugs. 62 (14): 2089–126. doi:10.2165/00003495-200262140-00012. PMID 12269857. S2CID 46974328.
- ^ Fonseca, Rafael; Tefferi, Ayalew; Strickler, John G. (1997). "Follicular dendritic cell sarcoma mimicking diffuse large cell lymphoma: A case report". American Journal of Hematology. 55 (3): 148–55. doi:10.1002/(SICI)1096-8652(199707)55:3<148::AID-AJH6>3.0.CO;2-S. PMID 9256295.
- ^ Kosco, Marie H.; Gray, David (1992). "Signals Involved in Germinal Center Reactions". Immunological Reviews. 126: 63–76. doi:10.1111/j.1600-065X.1992.tb00631.x. PMID 1597321. S2CID 6172404.
- ^ Tew, John G.; Kosco, Marie H.; Burton, Gregory F.; Szakal, Andras K. (1990). "Follicular Dendritic Cells as Accessory Cells". Immunological Reviews. 117: 185–211. doi:10.1111/j.1600-065X.1990.tb00573.x. PMID 2258191. S2CID 5556197.
- ^ a b c d e f Fonseca, R.; Yamakawa, M.; Nakamura, S.; Van Heerde, P.; Miettinen, M.; Shek, T.W. H.; Jensen, O. Myhre; Rousselet, M. C.; Tefferi, A. (1998). "Follicular dendritic cell sarcoma and interdigitating reticulum cell sarcoma: A review". American Journal of Hematology. 59 (2): 161–7. doi:10.1002/(SICI)1096-8652(199810)59:2<161::AID-AJH10>3.0.CO;2-C. PMID 9766802.
- ^ Biddle, David A.; Ro, Jae Y.; Yoon, Gil S.; Yong, Yap-Whang H.; Ayala, Alberto G.; Ordonez, Nelson G.; Ro, J (2002). "Extranodal Follicular Dendritic Cell Sarcoma of the Head and Neck Region: Three New Cases, with a Review of the Literature". Modern Pathology. 15 (1): 50–8. doi:10.1038/modpathol.3880489. PMID 11796841.
- ^ Chen Tse-Ching; Kuo Tseng-tong; Ng Kwai-Fong (2001). "Follicular Dendritic Cell Tumor of the Liver: A Clinicopathologic and Epstein-Barr Virus Study of Two Cases". Modern Pathology. 14 (4): 354–360. doi:10.1038/modpathol.3880315. PMID 11301353.
- ^ Horiguchi H.; Matsui-Horiguchi M.; Sakata H.; Ichinose M.; Yamamoto T.; Fujiwara M.; Ohse H. (February 2004). "Inflammatory pseudotumor-like follicular dendritic cell tumor of the spleen". Pathology International. 54 (2): 124–131. doi:10.1111/j.1440-1827.2004.01589.x. PMID 14720144. S2CID 8651824.
- ^ a b Chan, John K. C.; Fletcher, Christopher D. M.; Nayler, Simon J.; Cooper, Kum (1997). "Follicular dendritic cell sarcoma". Cancer. 79 (2): 294–313. doi:10.1002/(SICI)1097-0142(19970115)79:2<294::AID-CNCR13>3.0.CO;2-W. PMID 9010103.
- ^ Ono, Yuri; Terashima, Kazuo; Liu, Aimin; Yokoyama, Munehiro; Yokoshima, Kazuhiro; Mizukami, Miki; Watanabe, Ken; Mochimaru, Yoko; et al. (2009). "Follicular dendritic cell sarcoma with microtubuloreticular structure and virus-like particle productionin vitro". Pathology International. 59 (5): 332–44. doi:10.1111/j.1440-1827.2009.02375.x. PMID 19432677. S2CID 41080132.
- ^ Grogg, Karen L; Macon, William R; Kurtin, Paul J; Nascimento, Antonio G (2004). "A survey of clusterin and fascin expression in sarcomas and spindle cell neoplasms: strong clusterin immunostaining is highly specific for follicular dendritic cell tumor". Modern Pathology. 18 (2): 260–6. doi:10.1038/modpathol.3800294. PMID 15467709.
- ^ a b c Hanahan, Douglas; Weinberg, Robert A. (2011). "Hallmarks of Cancer: The Next Generation". Cell. 144 (5): 646–74. doi:10.1016/j.cell.2011.02.013. PMID 21376230.
- ^ Nicolini, A; Mancini, P; Ferrari, P; Anselmi, L; Tartarelli, G; Bonazzi, V; Carpi, A; Giardino, R (2004). "Oral low-dose cyclophosphamide in metastatic hormone refractory prostate cancer (MHRPC)". Biomedicine & Pharmacotherapy. 58 (8): 447–50. doi:10.1016/j.biopha.2004.08.006. PMID 15464874.
- ^ Nelius, Thomas; Klatte, Tobias; Riese, Werner; Haynes, Allan; Filleur, Stephanie (2009). "Clinical outcome of patients with docetaxel-resistant hormone-refractory prostate cancer treated with second-line cyclophosphamide-based metronomic chemotherapy". Medical Oncology. 27 (2): 363–7. doi:10.1007/s12032-009-9218-8. PMID 19365737. S2CID 27539332.
- ^ Wendel, Hans-Guido; Stanchina, Elisa de; Fridman, Jordan S.; Malina, Abba; Ray, Sagarika; Kogan, Scott; Cordon-Cardo, Carlos; Pelletier, Jerry; Lowe, Scott W. (2004). "Survival signalling by Akt and eIF4E in oncogenesis and cancer therapy". Nature. 428 (6980): 332–7. Bibcode:2004Natur.428..332W. doi:10.1038/nature02369. PMID 15029198. S2CID 4426215.
- ^ a b Chen, Juhua; Somanath, Payaningal R; Razorenova, Olga; Chen, William S; Hay, Nissim; Bornstein, Paul; Byzova, Tatiana V (2005). "Akt1 regulates pathological angiogenesis, vascular maturation and permeability in vivo". Nature Medicine. 11 (11): 1188–96. doi:10.1038/nm1307. PMC 2277080. PMID 16227992.
- ^ a b Depas, T; Spitaleri, G; Pruneri, G; Curigliano, G; Noberasco, C; Luini, A; Andreoni, B; Testori, A; Debraud, F (2008). "Dendritic cell sarcoma: An analytic overview of the literature and presentation of original five cases". Critical Reviews in Oncology/Hematology. 65 (1): 1–7. doi:10.1016/j.critrevonc.2007.06.003. PMID 17658269.
- ^ Pathan, N; Aime-Sempe, C; Kitada, S; Basu, A; Haldar, S; Reed, JC (2001). "Microtubule-Targeting Drugs Induce Bcl-2 Phosphorylation and Association with Pin1". Neoplasia. 3 (6): 550–9. doi:10.1038/sj.neo.7900213. PMC 1506558. PMID 11774038.
- ^ Mini, E.; Nobili, S; Caciagli, B; Landini, I; Mazzei, T (2006). "Cellular pharmacology of gemcitabine". Annals of Oncology. 17: v7–12. doi:10.1093/annonc/mdj941. PMID 16807468.
- ^ Leu, K. M.; Ostruszka, LJ; Shewach, D; Zalupski, M; Sondak, V; Biermann, JS; Lee, JS; Couwlier, C; et al. (2004). "Laboratory and Clinical Evidence of Synergistic Cytotoxicity of Sequential Treatment With Gemcitabine Followed by Docetaxel in the Treatment of Sarcoma". Journal of Clinical Oncology. 22 (9): 1706–12. doi:10.1200/JCO.2004.08.043. PMID 15117993.
- ^ Bay, Jacques-Olivier; Ray-Coquard, Isabelle; Fayette, Jérôme; Leyvraz, Serge; Cherix, Stephane; Piperno-Neumann, Sophie; Chevreau, Christine; Isambert, Nicolas; et al. (2006). "Docetaxel and gemcitabine combination in 133 advanced soft-tissue sarcomas: A retrospective analysis". International Journal of Cancer. 119 (3): 706–11. doi:10.1002/ijc.21867. PMID 16496406.